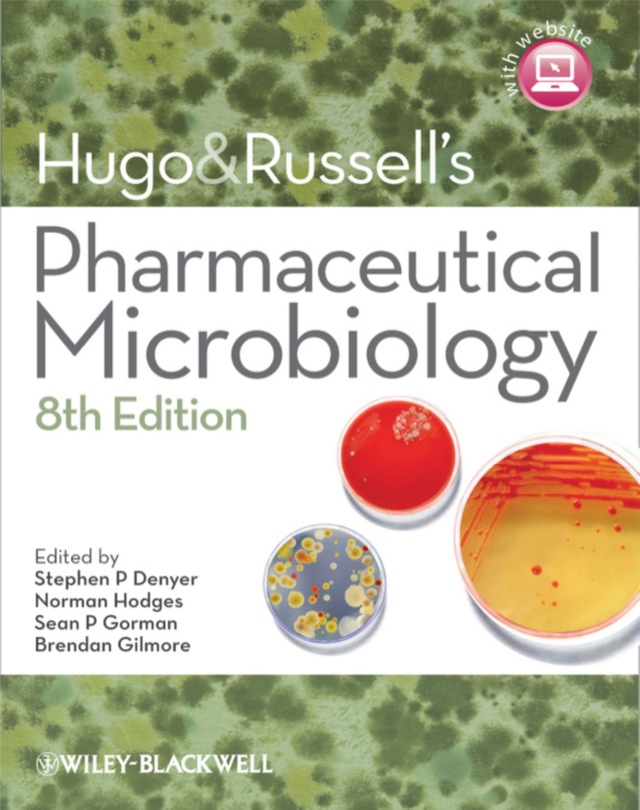
Hugo and Russels Pharmaceutical Microbiology

-
 Sold out
Sold outUnderstanding the Theories of Cosmology and Astronomy
1ST -2021ISBN: 9781685388003Regular price POARegular priceUnit price / perWasSale price Now R 619.99Sold out -
 Sold out
Sold outHubbles Universe Greatest Discoveries and Latest Images
1ST - 2017ISBN: 9781770859975Regular price POARegular priceUnit price / perWasSale price Now R 989.99Sold out -
 Sold out
Sold outReady Set Science! Putting Research to Work in K 8 Science Classrooms
1ST - 2007ISBN: 9780309106146Regular price POARegular priceUnit price / perWasSale price Now R 1,029.99Sold out -
 Sold out
Sold outBackyard Astronomers Guide
4TH - 2021ISBN: 9780228103271Regular price POARegular priceUnit price / perWasSale price Now R 1,149.99Sold out -
 Sold out
Sold outIntroduction to Astronomy and Cosmology
1ST - 2008ISBN: 9780470033340Regular price POARegular priceUnit price / perWasSale price Now R 1,369.99Sold out -
 Sold out
Sold outAstronomy and Astrophysics Notes Problems and Solutions
1ST- 2012ISBN: 9781304102126Regular price POARegular priceUnit price / perWasSale price Now R 1,019.99Sold out -
 Sold out
Sold outEnd of Everything
1ST - 2021ISBN: 9780141989587Regular price POARegular priceUnit price / perWasSale price Now R 295.99Sold out -
 Sold out
Sold outStargazing From Game Reserves in Southern Africa
2ND - 2025ISBN: 9781779890290Regular price POARegular priceUnit price / perWasSale price Now R 269.99Sold out -
 Sold out
Sold outTurn Left at Orion Hundreds of Night Sky Objects to See in a Home Telescope and How to Find Them
5TH - 2019ISBN: 9781108457569Regular price POARegular priceUnit price / perWasSale price Now R 769.99Sold out -
 Sold out
Sold outHow Science Works the Facts Visually Explained
1ST - 2018ISBN: 9780241287279Regular price POARegular priceUnit price / perWasSale price Now R 385.00Sold out -
 Sold out
Sold outFundamentals of Particle Physics Understanding the Standard Model
1ST - 2023ISBN: 9781009171588Regular price POARegular priceUnit price / perWasSale price Now R 1,299.99Sold out -
 Sold out
Sold outIntroduction to the Statistical Physics of Integrable Many Body Systems
1ST - 2013ISBN: 9781107030435Regular price POARegular priceUnit price / perWasSale price Now R 3,789.99Sold out -
 Sold out
Sold outExtreme Physics Properties and Behavior of Matter at Extreme Conditions
1ST - 2013ISBN: 9781107019676Regular price POARegular priceUnit price / perWasSale price Now R 2,459.99Sold out -
 Sold out
Sold outThink Bayes Bayesian Statistics in Python
2ND - 2021ISBN: 9781492089469Regular price POARegular priceUnit price / perWasSale price Now R 1,479.99Sold out -
 Sold out
Sold outPrinceton Guide to Advanced Physics
1ST - 1996ISBN: 9780691026626Regular price POARegular priceUnit price / perWasSale price Now R 1,469.99Sold out -
 Sold out
Sold outPhysics of Quantum Rings
3RD - 2025ISBN: 9783031859144Regular price POARegular priceUnit price / perWasSale price Now R 3,129.99Sold out -
 Sold out
Sold outThinking in Physics the Pleasure of Reasoning and Understanding
1ST - 2014ISBN: 9789401786652Regular price POARegular priceUnit price / perWasSale price Now R 2,239.99Sold out -

Microbiology an Introduction (Global Edition)
14TH - 2025ISBN: 9781292737423Regular price R 2,039.99Regular priceUnit price / perWasSale price Now R 2,039.99 -
 Sold out
Sold outSas for Linear Models
4TH - 2002ISBN: 97804712217463Regular price POARegular priceUnit price / perWasSale price Now R 2,296.50Sold out -

Microbiology an Introduction Global Edition Modified Mastering Biology With Pearson Etext Package
14TH - 2025ISBN: 9781292469409Regular price R 2,389.99Regular priceUnit price / perWasSale price Now R 2,389.99 -
 Sold out
Sold outChemistry and Physics of Energetic Materials (H/C)
1ST - 1990ISBN: 9780792307457Regular price POARegular priceUnit price / perWasSale price Now R 6,879.99Sold out -
 Sold out
Sold outPartial Differential Equations an Intro
2ND - 2008ISBN: 9780470054567Regular price POARegular priceUnit price / perWasSale price Now R 4,409.99Sold out -
 Sold out
Sold outPrinciple of Relativity With Applications to Physical Science
1ST - 2021ISBN: 9789354419294Regular price POARegular priceUnit price / perWasSale price Now R 869.99Sold out -
 Sold out
Sold outThermodynamics Statistical Thermodynamics and Kinetics (Physical Chemistry)(Global Edition)
4TH - 2020ISBN: 9781292347707Regular price POARegular priceUnit price / perWasSale price Now R 1,339.99Sold out -

Microbiology for Dummies
1ST - 2019ISBN: 9781119544760Regular price R 727.00Regular priceUnit price / perWasSale price Now R 727.00 -

Postharvest Biology and Nanotechnology
1ST - 2018ISBN: 9781119289456Regular price R 5,027.00Regular priceUnit price / perWasSale price Now R 5,027.00 -

Master Dentistry Oral Anatomy Histology Physiology and Biochemistry Oral Biology (Volume 3)
1ST - 2010ISBN: 9780702044588Regular price R 1,921.00Regular priceUnit price / perWasSale price Now R 1,921.00 -

Brs Microbiology and Immunology
6TH - 2013ISBN: 9781469852416Regular price R 856.00Regular priceUnit price / perWasSale price Now R 856.00 -
Hugo and Russels Pharmaceutical Microbiology
8TH - 2011ISBN: 9781118774649Regular price R 2,209.00Regular priceUnit price / perWasSale price Now R 2,209.00 -

Essential Microbiology
2ND - 2012ISBN: 9781118527283Regular price R 2,383.00Regular priceUnit price / perWasSale price Now R 2,383.00 -

Microbiology
3RD - 2012ISBN: 9781469854106Regular price R 1,524.00Regular priceUnit price / perWasSale price Now R 1,524.00 -

Leading Primary Mathematics
1ST - 2019ISBN: 9781526479112Regular price R 656.00Regular priceUnit price / perWasSale price Now R 656.00 -

Essential Maths for Business and Management
1ST - 2013ISBN: 9781137041012Regular price R 1,165.00Regular priceUnit price / perWasSale price Now R 1,165.00 -

Essential Maths for Geoscientists an Introduction
1ST - 2014ISBN: 9781118527054Regular price R 2,180.00Regular priceUnit price / perWasSale price Now R 2,180.00 -

Enriching Mathematics in the Primary Curriculum
1ST - 2019ISBN: 9781526489708Regular price R 621.00Regular priceUnit price / perWasSale price Now R 621.00 -

Understanding Lte With Matlab From Mathematical Modeling to Simulation and Prototyping
1ST - 2013ISBN: 9781118872758Regular price R 3,197.00Regular priceUnit price / perWasSale price Now R 3,197.00